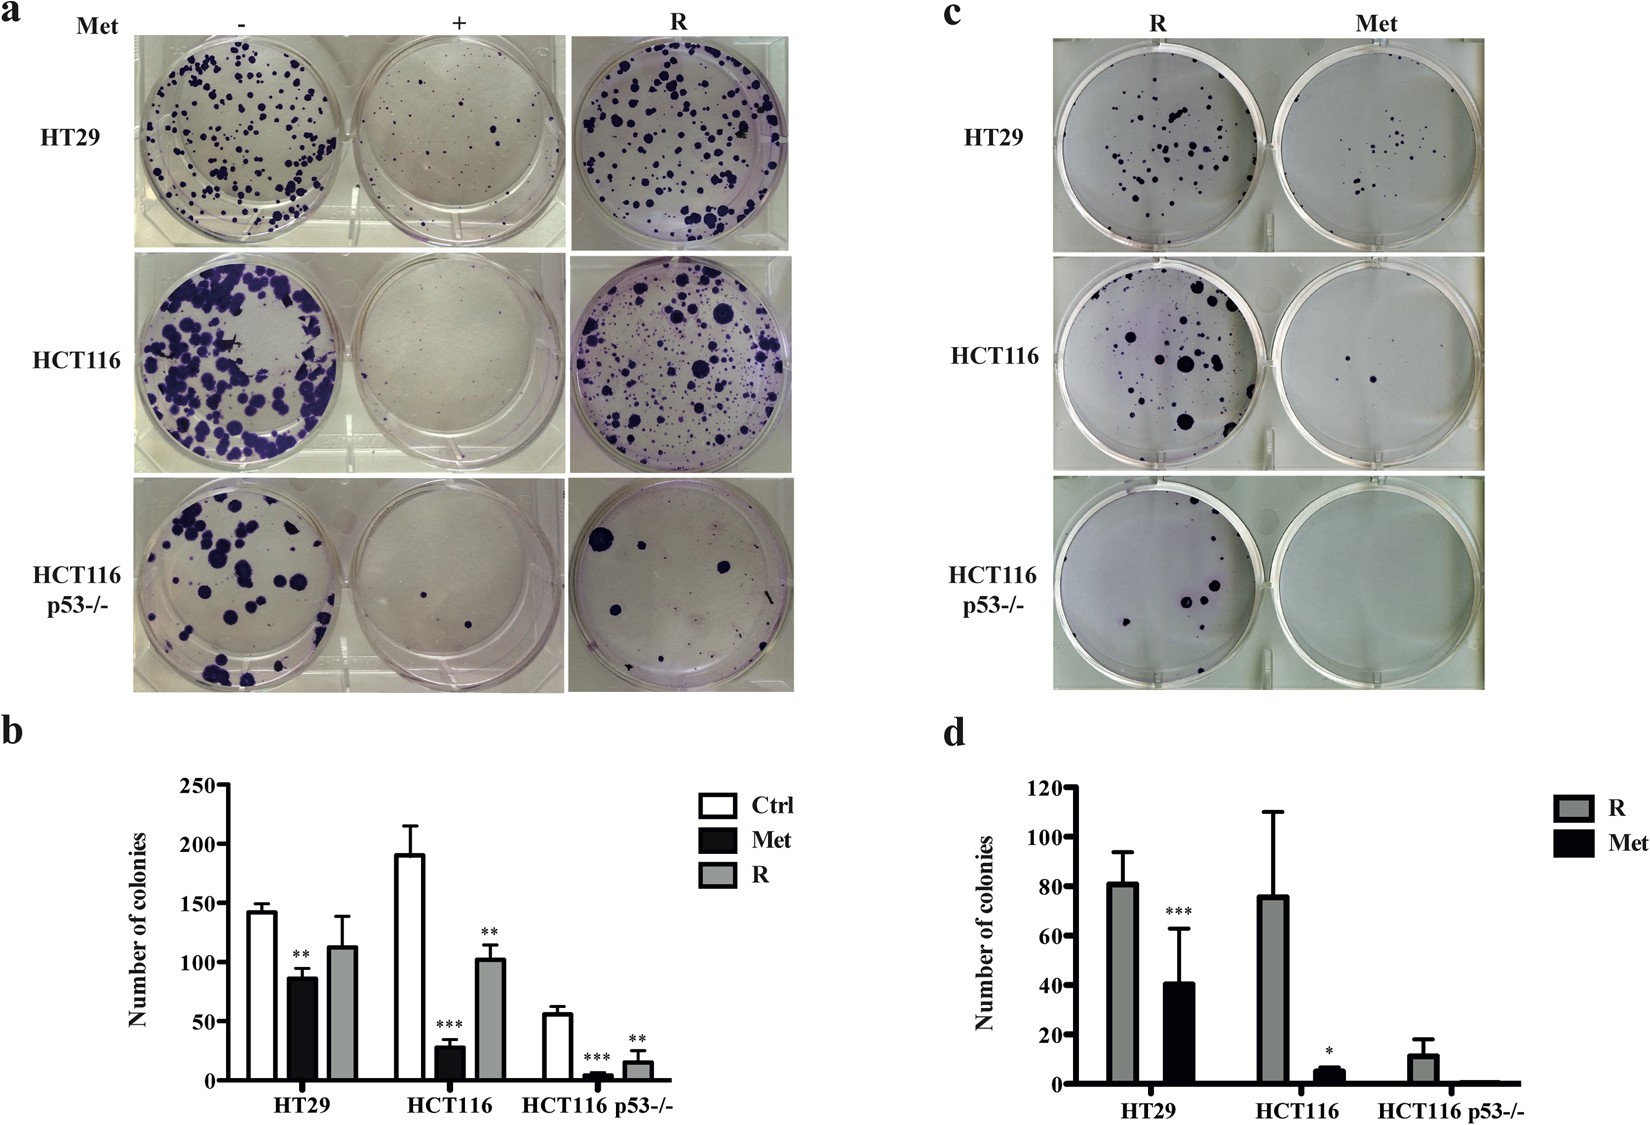
Figure 4

Figure 4
Metformin (Met) reversibly inhibits colony formation. (a) One hundred cells were grown for 12 days in 6-well plates with or without Met (5 mM). The “rescued” colonies (R) are cells treated with Met for 12 days and grown for a further 12 days in fresh complete medium without Met. (b) Graphic representation of the results. The bars indicate the mean value ± SD of three independent experiments (**P < 0.01, ***P < 0.001). (c) One hundred “rescued” cells (R) were grown for 12 days in 6-well plates in presence or absence of Met. (d) Graphic representation of the results. The bars indicate the mean value ± SD of three independent experiments (*P < 0.05, ***P < 0.001).